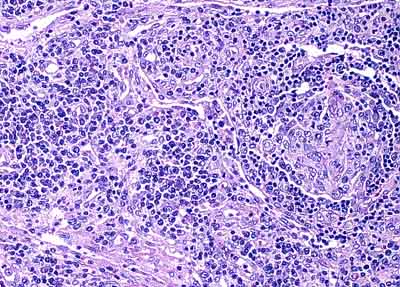
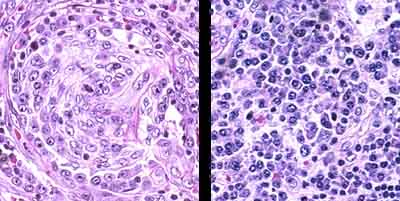

Go to:

TOC
|
Aids Lymphadenopathy: Follicular Involution
Left: a proliferation of vessels and plasma cells. Right: an involuted follicle |
Left: high power view of involuted follicle with mainly dendritic and endothelial cells remaining. Right: plasmacytosis. |
Table of Contents
|